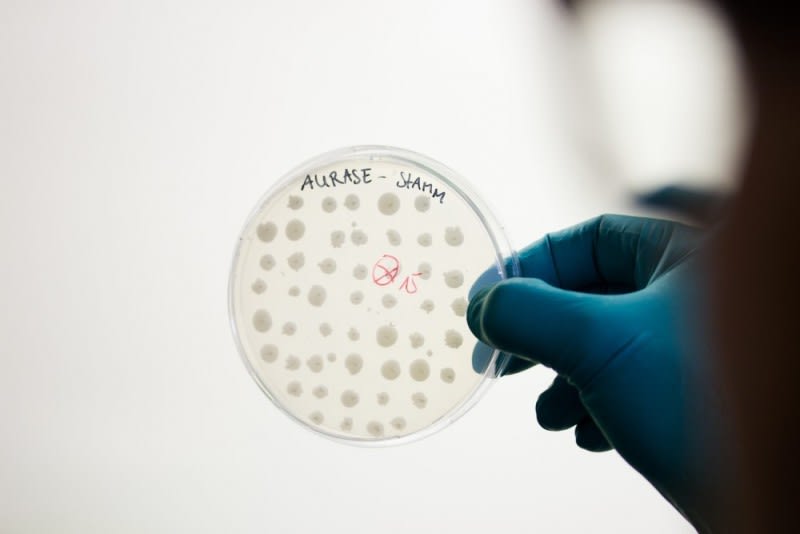
SolasCure announces Series A raise

Posted 28th March 2024
Posted 2 years ago
By GS Verde Group
Travel management company makes strategic acquisition to expand group
QA Travel, a leading travel group, has acquired an Aberdeen-based travel company in a deal advised on by the GS Verde Group.